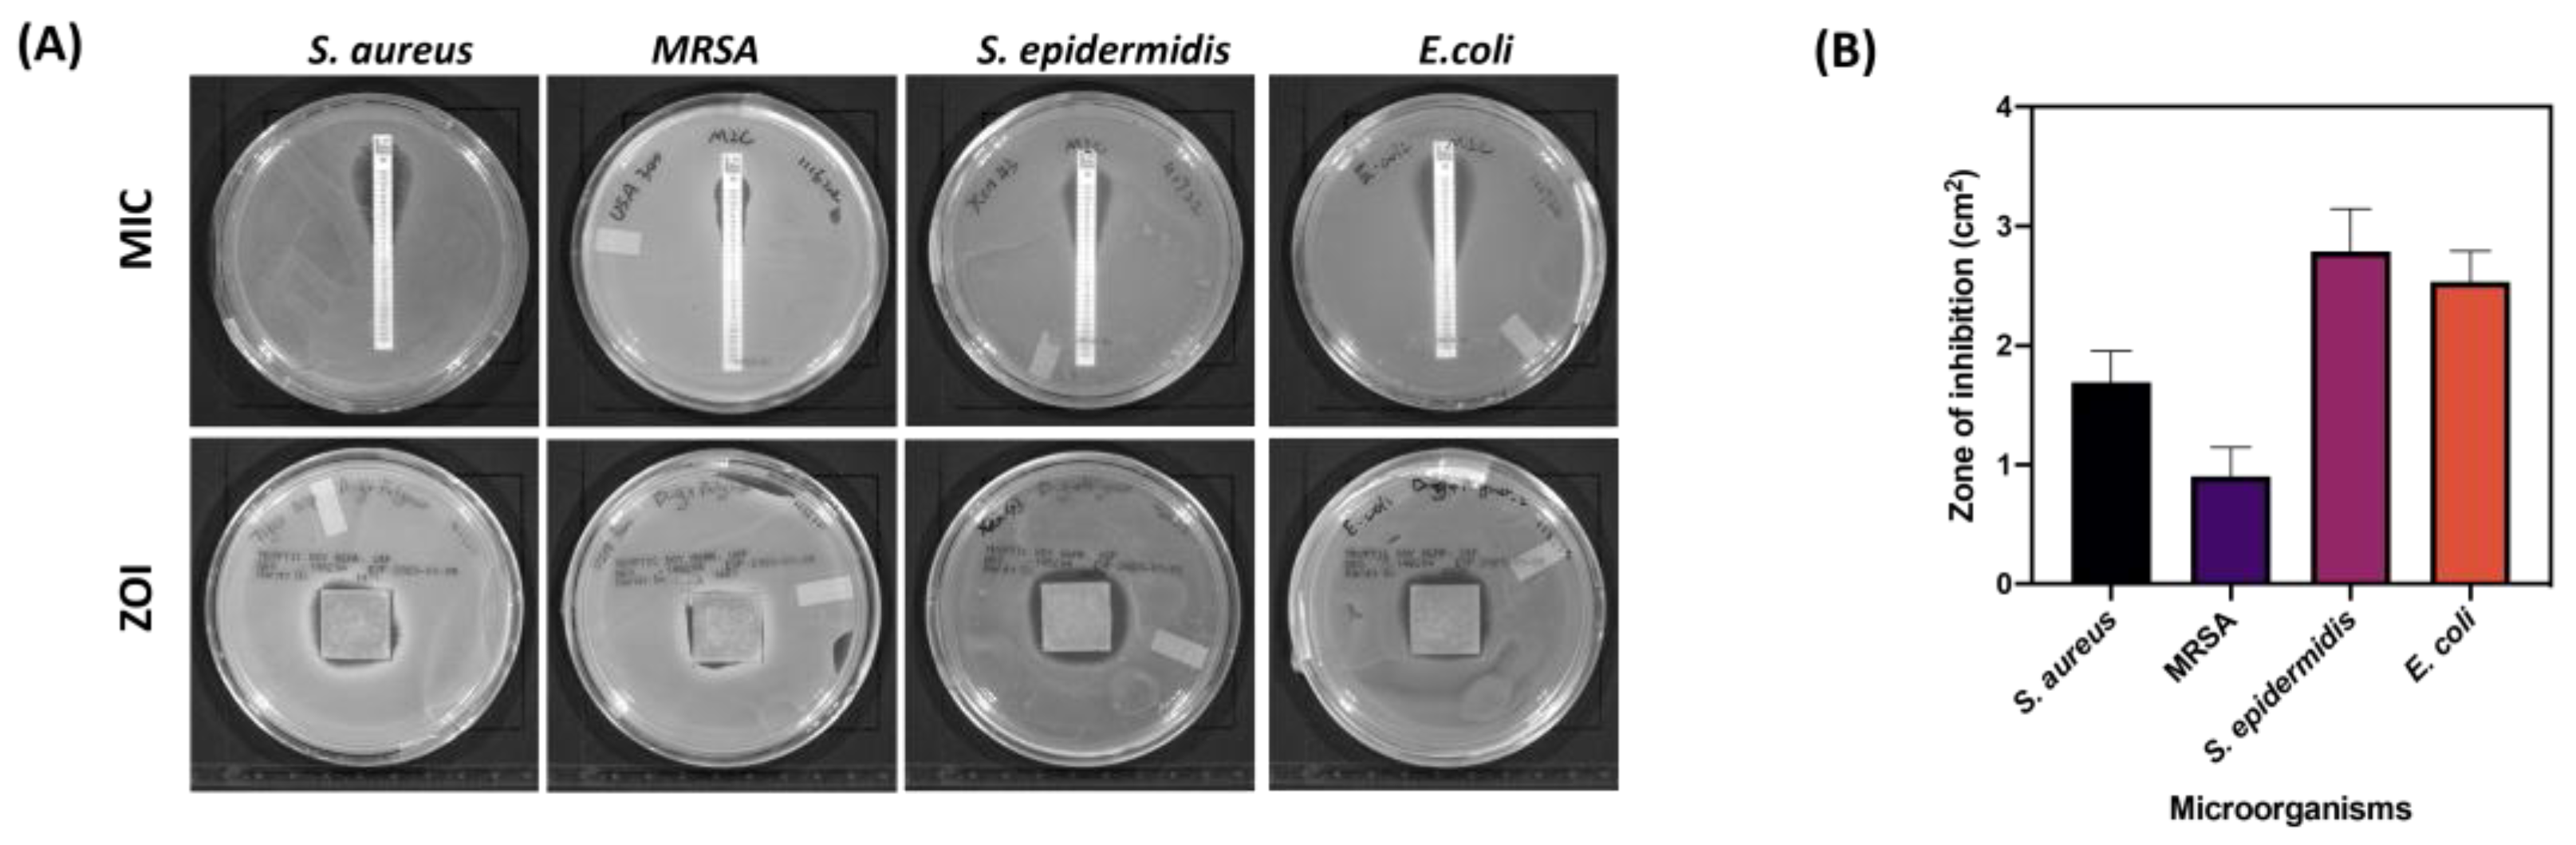
Pharmaceutics 17 00911 g010 Pharmaceutics 17 00911 g010

Amikacin Coated 3D-Printed Metal Devices for Prevention of Postsurgical Infections (PSIs)
Abstract
1. Introduction
2. Materials and Methods
2.1. Materials
2.2. Implant Prototypes Fabrication
2.3. Preparation of Hydrogel for 3DP-Based Coating
2.4. Implant Coating with 3D-Printing and Drop Casting Technique
2.5. Characterizations of Coated Implants
2.5.1. Surface Morphology
2.5.2. Roughness and Thickness Measurement
2.5.3. Viscosity Assessment
2.5.4. Coating Efficiency
2.5.5. Drug Content Uniformity
2.5.6. Differential Scanning Calorimetry (DSC)
2.6. In Vitro Drug Release
2.7. HPLC Quantification of Amikacin
2.7.1. Method Development
2.7.2. Instrumentation and Chromatographic Conditions
2.7.3. Preparation of Standard Solutions and Sample Solutions
2.7.4. Method Validation
Linearity and Sensitivity
Accuracy and Precision
Robustness
2.8. Antimicrobial Study
2.8.1. Minimum Inhibitory Concentrations (MICs) Determination
2.8.2. Antibacterial Efficacy Study
2.8.3. Antibacterial Longevity Study
2.9. Statistical Analysis
3. Results
3.1. Coating Technique Optimization
3.2. Physical Characterizations of Coated Implants
3.2.1. Surface Morphology Evaluation
3.2.2. Roughness and Thickness Measurement
3.2.3. Viscosity Assessment
3.2.4. Coating Efficiency and Content Uniformity of Coated Implants
3.2.5. Thermal Analysis of Polymeric Layer
3.3. In Vitro Release of Amikacin
3.4. Development and Validation of HPLC Method for Amikacin Analysis
3.5. Antimicrobial Study
4. Discussion
4.1. DP Coating and Physical Characteristics of Coated Implants
4.2. In Vitro Amikacin Release Profile with Different Molecular Weight Chitosan Coating and Drug Percentage Loading
4.3. Antibacterial Efficacy of Amikacin-Coated 3DP Implants
5. Conclusions
Supplementary Materials
Author Contributions
Funding
Institutional Review Board Statement
Informed Consent Statement
Data Availability Statement
Conflicts of Interest
Abbreviations
| PSIs | Post-surgical infections |
| 3DP | 3D printing |
| AM | Additive manufacturing |
| SS | Stainless steels |
| CAD | Computer-aided design |
| AMK | Amikacin |
| PLGA | Poly lactic-co-glycolic acid |
| MIC | Minimal inhibitory concentration |
| ZOI | Zone of inhibition |
| MRSA | Methicillin-resistant Staphylococcus aureus |
| TSB | Tryptic soy broth |
| LMW | Low molecular weight |
| MMW | Medium molecular weight |
| PBS | Phosphate-buffered saline |
| HPLC | High-pressure liquid chromatography |
| FDNB | 1-fluoro-2,4-dinitrobenzene |
| LOD | Limit of detection |
| LLOQ | Lower limit of quantification |
| RSD | Relative standard deviation |
References
- Chen, X.; Zhou, J.; Qian, Y.; Zhao, L. Antibacterial coatings on orthopedic implants. Mater. Today Bio 2023, 19, 100586. [Google Scholar] [CrossRef] [PubMed]
- Kim, T.; See, C.W.; Li, X.; Zhu, D. Orthopedic implants and devices for bone fractures and defects: Past, present and perspective. Eng. Regen. 2020, 1, 6–18. [Google Scholar] [CrossRef]
- Ryan, S.P.; Stambough, J.B.; Huddleston, J.I.; Levine, B.R. Highlights of the 2023 American Joint Replacement Registry Annual Report. Arthroplast. Today 2024, 26, 101325. [Google Scholar] [CrossRef] [PubMed]
- Chua, K.; Khan, I.; Malhotra, R.; Zhu, D. Additive manufacturing and 3D printing of metallic biomaterials. Eng. Regen. 2021, 2, 288–299. [Google Scholar] [CrossRef]
- Lodhi, M.J.k.; Deen, K.M.; Greenlee-Wacker, M.C.; Haider, W. Additively manufactured 316L stainless steel with improved corrosion resistance and biological response for biomedical applications. Addit. Manuf. 2019, 27, 8–19. [Google Scholar] [CrossRef]
- Gurappa, I. Development of appropriate thickness ceramic coatings on 316 L stainless steel for biomedical applications. Surf. Coatings Technol. 2002, 161, 70–78. [Google Scholar] [CrossRef]
- Parsapour, A.; Khorasani, S.N.; Fathi, M.H. Effect of Surface Treatment and Metallic Coating on Corrosion Behavior and Biocompatibility of Surgical 316L Stainless Steel Implant. J. Mater. Sci. Technol. 2012, 28, 125–131. [Google Scholar] [CrossRef]
- Poudel, I.; Annaji, M.; Zhang, C.; Panizzi, P.R.; Arnold, R.D.; Kaddoumi, A.; Amin, R.H.; Lee, S.; Shamsaei, N.; Babu, R.J. Gentamicin Eluting 3D-Printed Implants for Preventing Post-Surgical Infections in Bone Fractures. Mol. Pharm. 2023, 20, 4236–4255. [Google Scholar] [CrossRef] [PubMed]
- Wu, Y.; Liu, J.; Kang, L.; Tian, J.; Zhang, X.; Hu, J.; Huang, Y.; Liu, F.; Wang, H.; Wu, Z. An overview of 3D printed metal implants in orthopedic applications: Present and future perspectives. Heliyon 2023, 9, e17718. [Google Scholar] [CrossRef] [PubMed]
- Bg, P.K.; Mehrotra, S.; Marques, S.M.; Kumar, L.; Verma, R. 3D printing in personalized medicines: A focus on applications of the technology. Mater. Today Commun. 2023, 35, 105875. [Google Scholar] [CrossRef]
- Khairallah, S.A.; Anderson, A.T.; Rubenchik, A.; King, W.E. Laser powder-bed fusion additive manufacturing: Physics of complex melt flow and formation mechanisms of pores, spatter, and denudation zones. Acta Mater. 2016, 108, 36–45. [Google Scholar] [CrossRef]
- King, W.E.; Anderson, A.T.; Ferencz, R.M.; Hodge, N.E.; Kamath, C.; Khairallah, S.A.; Rubenchik, A.M. Laser powder bed fusion additive manufacturing of metals; physics, computational, and materials challenges. Appl. Phys. Rev. 2015, 2, 041304. [Google Scholar] [CrossRef]
- Zitelli, C.; Folgarait, P.; Di Schino, A. Laser Powder Bed Fusion of Stainless Steel Grades: A Review. Metals 2019, 9, 731. [Google Scholar] [CrossRef]
- Safali, S.; Berk, T.; Makelov, B.; Acar, M.A.; Gueorguiev, B.; Pape, H.-C. The Possibilities of Personalized 3D Printed Implants—A Case Series Study. Medicina 2023, 59, 249. [Google Scholar] [CrossRef] [PubMed]
- Ackland, D.C.; Robinson, D.; Redhead, M.; Lee, P.V.S.; Moskaljuk, A.; Dimitroulis, G. A personalized 3D-printed prosthetic joint replacement for the human temporomandibular joint: From implant design to implantation. J. Mech. Behav. Biomed. Mater. 2017, 69, 404–411. [Google Scholar] [CrossRef] [PubMed]
- Poudel, I.; Annaji, M.; Arnold, R.D.; Kaddoumi, A.; Shamsaei, N.; Lee, S.; Pegues, J.; Ahmadi, Z.; Samani, M.M.; Corriveau, K.; et al. Dexamethasone Eluting 3D Printed Metal Devices for Bone Injuries. Ther. Deliv. 2020, 11, 373–386. [Google Scholar] [CrossRef] [PubMed]
- Trampuz, A.; Widmer, A.F. Infections associated with orthopedic implants. Curr. Opin. Infect. Dis. 2006, 19, 349–356. [Google Scholar] [CrossRef] [PubMed]
- Seidelman, J.L.; Mantyh, C.R.; Anderson, D.J. Surgical Site Infection Prevention. JAMA 2023, 329, 244–252. [Google Scholar] [CrossRef] [PubMed]
- Widmer, A.F. New Developments in Diagnosis and Treatment of Infection in Orthopedic Implants. Clin. Infect. Dis. 2001, 33, S94–S106. [Google Scholar] [CrossRef] [PubMed]
- Powell, C.A.; Mealey, B.L.; Deas, D.E.; McDonnell, H.T.; Moritz, A.J. Post-Surgical Infections: Prevalence Associated with Various Periodontal Surgical Procedures. J. Periodontol. 2005, 76, 329–333. [Google Scholar] [CrossRef] [PubMed]
- Tan, G.; Xu, J.; Chirume, W.M.; Zhang, J.; Zhang, H.; Hu, X. Antibacterial and Anti-Inflammatory Coating Materials for Orthopedic Implants: A Review. Coatings 2021, 11, 1401. [Google Scholar] [CrossRef]
- Montali, A. Antibacterial coating systems. Injury 2006, 37, S81–S86. [Google Scholar] [CrossRef] [PubMed]
- Ismat, A.; Walter, N.; Baertl, S.; Mika, J.; Lang, S.; Kerschbaum, M.; Alt, V.; Rupp, M. Antibiotic cement coating in orthopedic surgery: A systematic review of reported clinical techniques. J. Orthop. Traumatol. 2021, 22, 56. [Google Scholar] [CrossRef] [PubMed]
- Tiwari, A.; Sharma, P.; Vishwamitra, B.; Singh, G. Review on Surface Treatment for Implant Infection via Gentamicin and Antibiotic Releasing Coatings. Coatings 2021, 11, 1006. [Google Scholar] [CrossRef]
- Schmidmaier, G.; Lucke, M.; Wildemann, B.; Haas, N.P.; Raschke, M. Prophylaxis and treatment of implant-related infections by antibiotic-coated implants: A review. Injury 2006, 37, S105–S112. [Google Scholar] [CrossRef] [PubMed]
- Rahal, J.J.; Simberkoff, M.S.; Kagan, K.; Moldover, N.H. Bactericidal Efficacy of Sch 20569 and Amikacin Against Gentamicin-Sensitive and -Resistant Organisms. Antimicrob. Agents Chemother. 1976, 9, 595–599. [Google Scholar] [CrossRef] [PubMed][Green Version]
- Ramirez, M.S.; Tolmasky, M.E. Amikacin: Uses, Resistance, and Prospects for Inhibition. Molecules 2017, 22, 2267. [Google Scholar] [CrossRef] [PubMed]
- Maxwell, A.; Ghate, V.; Aranjani, J.; Lewis, S. Breaking the barriers for the delivery of amikacin: Challenges, strategies, and opportunities. Life Sci. 2021, 284, 119883. [Google Scholar] [CrossRef] [PubMed]
- Kawaguchi, H. Discovery, Chemistry, and Activity of Amikacin. J. Infect. Dis. 1976, 134, S242–S248. [Google Scholar] [CrossRef] [PubMed]
- Saberi, A.; Bakhsheshi-Rad, H.R.; Abazari, S.; Ismail, A.F.; Sharif, S.; Ramakrishna, S.; Daroonparvar, M.; Berto, F. A Comprehensive Review on Surface Modifications of Biodegradable Magnesium-Based Implant Alloy: Polymer Coatings Opportunities and Challenges. Coatings 2021, 11, 747. [Google Scholar] [CrossRef]
- Azmana, M.; Mahmood, S.; Hilles, A.R.; Rahman, A.; Bin Arifin, M.A.; Ahmed, S. A review on chitosan and chitosan-based bionanocomposites: Promising material for combatting global issues and its applications. Int. J. Biol. Macromol. 2021, 185, 832–848. [Google Scholar] [CrossRef] [PubMed]
- Dodane, V.; Vilivalam, V.D. Pharmaceutical applications of chitosan. Pharm. Sci. Technol. Today 1998, 1, 246–253. [Google Scholar] [CrossRef]
- Sabaeifard, P.; Abdi-Ali, A.; Soudi, M.R.; Gamazo, C.; Irache, J.M. Amikacin loaded PLGA nanoparticles against Pseudomonas aeruginosa. Eur. J. Pharm. Sci. 2016, 93, 392–398. [Google Scholar] [CrossRef] [PubMed]
- Fatima, S.; Iqbal, Z.; Panda, A.; Samim, M.; Talegaonkar, S.; Ahmad, F.J. Polymeric nanoparticles as a platform for permeability enhancement of class III drug amikacin. Colloids Surfaces B Biointerfaces 2018, 169, 206–213. [Google Scholar] [CrossRef] [PubMed]
- Faludi, J.; Baumers, M.; Maskery, I.; Hague, R. Environmental Impacts of Selective Laser Melting: Do Printer, Powder, Or Power Dominate? J. Ind. Ecol. 2016, 21, S144–S156. [Google Scholar] [CrossRef]
- Nicoli, S.; Santi, P. Assay of amikacin in the skin by high-performance liquid chromatography. J. Pharm. Biomed. Anal. 2006, 41, 994–997. [Google Scholar] [CrossRef] [PubMed]
- Dash, S.; Murthy, P.N.; Nath, L.; Chowdhury, P. Kinetic modeling on drug release from controlled drug delivery systems. Acta Pol. Pharm. 2010, 67, 217–223. [Google Scholar] [PubMed]
- FDA. Bioanalytical Method Validation Guidance for Industry. Available online: https://www.fda.gov/files/drugs/published/Bioanalytical-Method-Validation-Guidance-for-Industry.pdf (accessed on 19 June 2025).
- Baker, C.N.; Thornsberry, C.; Hawkinson, R.W. Inoculum standardization in antimicrobial susceptibility testing: Evaluation of overnight agar cultures and the Rapid Inoculum Standardization System. J. Clin. Microbiol. 1983, 17, 450–457. [Google Scholar] [CrossRef] [PubMed]
- Kowalska-Krochmal, B.; Dudek-Wicher, R. The Minimum Inhibitory Concentration of Antibiotics: Methods, Interpretation, Clinical Relevance. Pathogens 2021, 10, 165. [Google Scholar] [CrossRef] [PubMed]
- Youssef, F.; Aly, U.F.; Abd El-Baky, R.M.; Waly, N.G. Comparative Study of Antibacterial Effects of Titanium Dioxide Nanoparticles Alone and in Combination with Antibiotics on MDR Pseudomonas aeruginosa Strains. Int. J. Nanomed. 2020, 15, 3393–3404. [Google Scholar] [CrossRef] [PubMed]
- Silva, A.T.C.R.; Cardoso, B.C.O.; e Silva, M.E.S.R.; Freitas, R.F.S.; Sousa, R.G. Synthesis, Characterization, and Study of PLGA Copolymer in Vitro Degradation. J. Biomater. Nanobiotechnology 2015, 6, 8–19. [Google Scholar] [CrossRef]
- Astete, C.E.; Sabliov, C.M. Synthesis and characterization of PLGA nanoparticles. J. Biomater. Sci. Polym. Ed. 2006, 17, 247–289. [Google Scholar] [CrossRef] [PubMed]
- Dehghanghadikolaei, A.; Fotovvati, B. Coating Techniques for Functional Enhancement of Metal Implants for Bone Replacement: A Review. Materials 2019, 12, 1795. [Google Scholar] [CrossRef] [PubMed]
- Adarkwa, E.; Roy, A.; Ohodnicki, J.; Lee, B.; Kumta, P.N.; Desai, S. 3D printing of drug-eluting bioactive multifunctional coatings for orthopedic applications. Int. J. Bioprinting 2023, 9, 158–175. [Google Scholar] [CrossRef] [PubMed]
- Martínez-Pérez, D.; Guarch-Pérez, C.; Purbayanto, M.A.K.; Choińska, E.; Riool, M.; Zaat, S.A.J.; Święszkowski, W. 3D-printed dual drug delivery nanoparticleloaded hydrogels to combat antibiotic-resistant bacteria. Int. J. Bioprinting 2023, 9, 64–79. [Google Scholar] [CrossRef] [PubMed]
- Rabea, E.I.; Badawy, M.E.-T.; Stevens, C.V.; Smagghe, G.; Steurbaut, W. Chitosan as Antimicrobial Agent: Applications and Mode of Action. Biomacromolecules 2003, 4, 1457–1465. [Google Scholar] [CrossRef] [PubMed]
- Bohara, S.; Suthakorn, J. Surface coating of orthopedic implant to enhance the osseointegration and reduction of bacterial colonization: A review. Biomater. Res. 2022, 26, 1–17. [Google Scholar] [CrossRef] [PubMed]
- Yu, K.; Hou, J.; Jin, Z.; Wu, K.; Xu, S.; Yang, N.; Shen, Y.; Tang, T.; Guo, S. A cochlear implant loaded with dexamethasone and coated with hyaluronic acid to inhibit fibroblast adhesion and proliferation. J. Drug Deliv. Sci. Technol. 2018, 46, 173–181. [Google Scholar] [CrossRef]
- Binder, L.; Santos, F.d.S.; da Conceição, T.F. The influence of molecular weight on the anticorrosion properties of chitosan coatings. Int. J. Biol. Macromol. 2024, 278, 134912. [Google Scholar] [CrossRef] [PubMed]
- El-Hafian, E.A.; Elgannoudi, E.S.; Mainal, A.; BIN Yahaya, A.H. Characterization of chitosan in acetic acid: Rheological and thermal studies. Turk. J. Chem. 2010, 34, 47–56. [Google Scholar] [CrossRef]
- Mehmood, Y.; Shahid, H.; Arshad, N.; Rasul, A.; Jamshaid, T.; Jamshaid, M.; Jamshaid, U.; Uddin, M.N.; Kazi, M. Amikacin-Loaded Chitosan Hydrogel Film Cross-Linked with Folic Acid for Wound Healing Application. Gels 2023, 9, 551. [Google Scholar] [CrossRef] [PubMed]
- Askarizadeh, M.; Esfandiari, N.; Honarvar, B.; Sajadian, S.A.; Azdarpour, A. Kinetic Modeling to Explain the Release of Medicine from Drug Delivery Systems. ChemBioEng Rev. 2023, 10, 1006–1049. [Google Scholar] [CrossRef]
- Ramteke, K.H.; Dighe, P.A.; Kharat, A.; Patil, S.V. Mathematical Models of Drug Dissolution: A Review. Sch. Acad. J. Pharm. 2014, 3, 388–396. [Google Scholar]
- Lakshani, N.; Wijerathne, H.S.; Sandaruwan, C.; Kottegoda, N.; Karunarathne, V. Release Kinetic Models and Release Mechanisms of Controlled-Release and Slow-Release Fertilizers. ACS Agric. Sci. Technol. 2023, 3, 939–956. [Google Scholar] [CrossRef]
- Boles, L.R.; Awais, R.; Beenken, K.E.; Smeltzer, M.S.; Haggard, W.O.; Jessica, A.J. Local Delivery of Amikacin and Vancomycin from Chitosan Sponges Prevent Polymicrobial Implant-Associated Biofilm. Mil. Med. 2018, 183, 459–465. [Google Scholar] [CrossRef] [PubMed]
- Lacy, M.K.; Nicolau, D.P.; Nightingale, C.H.; Quintiliani, R. The Pharmacodynamics of Aminoglycosides. Clin. Infect. Dis. 1998, 27, 23–27. [Google Scholar] [CrossRef] [PubMed]
- Kuti, J.L.; Wang, Q.; Chen, H.; Li, H.; Wang, H.; Nicolau, D.P. Defining the potency of amikacin against Escherichia coli, Klebsiella pneumoniae, Pseudomonas aeruginosa, and Acinetobacter baumannii derived from Chinese hospitals using CLSI and inhalation-based breakpoints. Infect. Drug Resist. 2018, 11, 783–790. [Google Scholar] [CrossRef] [PubMed]
- Campoccia, D.; Montanaro, L.; Arciola, C.R. A review of the clinical implications of anti-infective biomaterials and infection-resistant surfaces. Biomaterials 2013, 34, 8018–8029. [Google Scholar] [CrossRef] [PubMed]
- Kato, H.; Hagihara, M.; Hirai, J.; Sakanashi, D.; Suematsu, H.; Nishiyama, N.; Koizumi, Y.; Yamagishi, Y.; Matsuura, K.; Mikamo, H. Evaluation of Amikacin Pharmacokinetics and Pharmacodynamics for Optimal Initial Dosing Regimen. Drugs RD 2017, 17, 177–187. [Google Scholar] [CrossRef] [PubMed]
- Dash, M.; Chiellini, F.; Ottenbrite, R.M.; Chiellini, E. Chitosan—A versatile semi-synthetic polymer in biomedical applications. Prog. Polym. Sci. 2011, 36, 981–1014. [Google Scholar] [CrossRef]
- Makadia, H.K.; Siegel, S.J. Poly lactic-co-glycolic acid (PLGA) As biodegradable controlled drug delivery carrier. Polymers 2011, 3, 1377–1397. [Google Scholar] [CrossRef] [PubMed]
- Costerton, J.; Montanaro, L.; Arciola, C. Biofilm in Implant Infections: Its Production and Regulation. Int. J. Artif. Organs 2005, 28, 1062–1068. [Google Scholar] [CrossRef] [PubMed]
- Campoccia, D.; Montanaro, L.; Arciola, C.R. The significance of infection related to orthopedic devices and issues of antibiotic resistance. Biomaterials 2006, 27, 2331–2339. [Google Scholar] [CrossRef] [PubMed]

| Coating and Printing Parameters | Details |
|---|---|
| Concentration of chitosan | 2% (w/v) LMW or MMW chitosan in 1% (v/v) acetic acid |
| Amikacin:chitosan ratio | 1:10 |
| Printing head | Syringe-extrusion |
| Nozzle internal diameter | 0.25 mm (25-gauge) |
| Syringe pump | 2.5 mL |
| Platform temperature | Room temperature |
| Printing speed | 2 mm/s |
| Printing time | 6.5 min |
| Printing volume | 457 μL |
| Printing size | 1.5 cm × 1.5 cm × 0.3 cm |
| Extrusion rate | 1 μL/s |
| Retract volume | 10 μL |
| Infill pattern | Grid |
| Infill density | 98% |
| First layer height | 0.25 mm |
| Concentration of PLGA | 50 mg/mL in acetone |
| Volume of PLGA coating | 500 μL/layer |
| Mathematical Model | Plot | Parameters Studied | 5% (w/w) AMK- LMW- PLGA | 10% (w/w) AMK- LMW- PLGA | 5% (w/w) AMK-MMW-PLGA | 10% (w/w) AMK-MMW-PLGA |
|---|---|---|---|---|---|---|
| Zero-order | Cumulative release (%) vs. Time | R2 | 0.9825 | 0.973 | 0.9907 | 0.9405 |
| k0 | 5.1428 | 7.2632 | 4.1865 | 4.6997 | ||
| First-order | Log (% cumulative release) vs. Time | R2 | 0.8492 | 0.9381 | 0.8047 | 0.743 |
| k1 | 0.164 | 0.1642 | 0.1564 | 0.1274 | ||
| Higuchi | Cumulative release (%) vs. Sq. root of time | R2 | 0.9282 | 0.9018 | 0.9823 | 0.9555 |
| kH | 14.684 | 20.118 | 12.246 | 14.159 | ||
| Hixson-Crowell | Cube root of cumulative release (%) vs. Time | R2 | 0.9725 | 0.9666 | 0.9936 | 0.9964 |
| kH-C | 0.093 | 0.1373 | 0.0732 | 0.0854 | ||
| Korsmeyer-Peppas | Log (% cumulative release) vs. Log (time) | R2 | 0.9354 | 0.9289 | 0.9944 | 0.9819 |
| n | 0.6651 | 0.6059 | 0.6549 | 0.5397 | ||
| kK-P | 9.1285 | 12.574 | 8.4551 | 13.57 |
Disclaimer/Publisher’s Note: The statements, opinions and data contained in all publications are solely those of the individual author(s) and contributor(s) and not of MDPI and/or the editor(s). MDPI and/or the editor(s) disclaim responsibility for any injury to people or property resulting from any ideas, methods, instructions or products referred to in the content. |
© 2025 by the authors. Licensee MDPI, Basel, Switzerland. This article is an open access article distributed under the terms and conditions of the Creative Commons Attribution (CC BY) license (https://creativecommons.org/licenses/by/4.0/).
Share and Cite
Zhang, C.; Poudel, I.; Mita, N.; Kang, X.; Annaji, M.; Lee, S.; Panizzi, P.; Shamsaei, N.; Fasina, O.; Babu, R.J.; et al. Amikacin Coated 3D-Printed Metal Devices for Prevention of Postsurgical Infections (PSIs). Pharmaceutics 2025, 17, 911. https://doi.org/10.3390/pharmaceutics17070911
Zhang C, Poudel I, Mita N, Kang X, Annaji M, Lee S, Panizzi P, Shamsaei N, Fasina O, Babu RJ, et al. Amikacin Coated 3D-Printed Metal Devices for Prevention of Postsurgical Infections (PSIs). Pharmaceutics. 2025; 17(7):911. https://doi.org/10.3390/pharmaceutics17070911
Chicago/Turabian StyleZhang, Chu, Ishwor Poudel, Nur Mita, Xuejia Kang, Manjusha Annaji, Seungjong Lee, Peter Panizzi, Nima Shamsaei, Oladiran Fasina, R. Jayachandra Babu, and et al. 2025. "Amikacin Coated 3D-Printed Metal Devices for Prevention of Postsurgical Infections (PSIs)" Pharmaceutics 17, no. 7: 911. https://doi.org/10.3390/pharmaceutics17070911
APA StyleZhang, C., Poudel, I., Mita, N., Kang, X., Annaji, M., Lee, S., Panizzi, P., Shamsaei, N., Fasina, O., Babu, R. J., & Arnold, R. D. (2025). Amikacin Coated 3D-Printed Metal Devices for Prevention of Postsurgical Infections (PSIs). Pharmaceutics, 17(7), 911. https://doi.org/10.3390/pharmaceutics17070911

